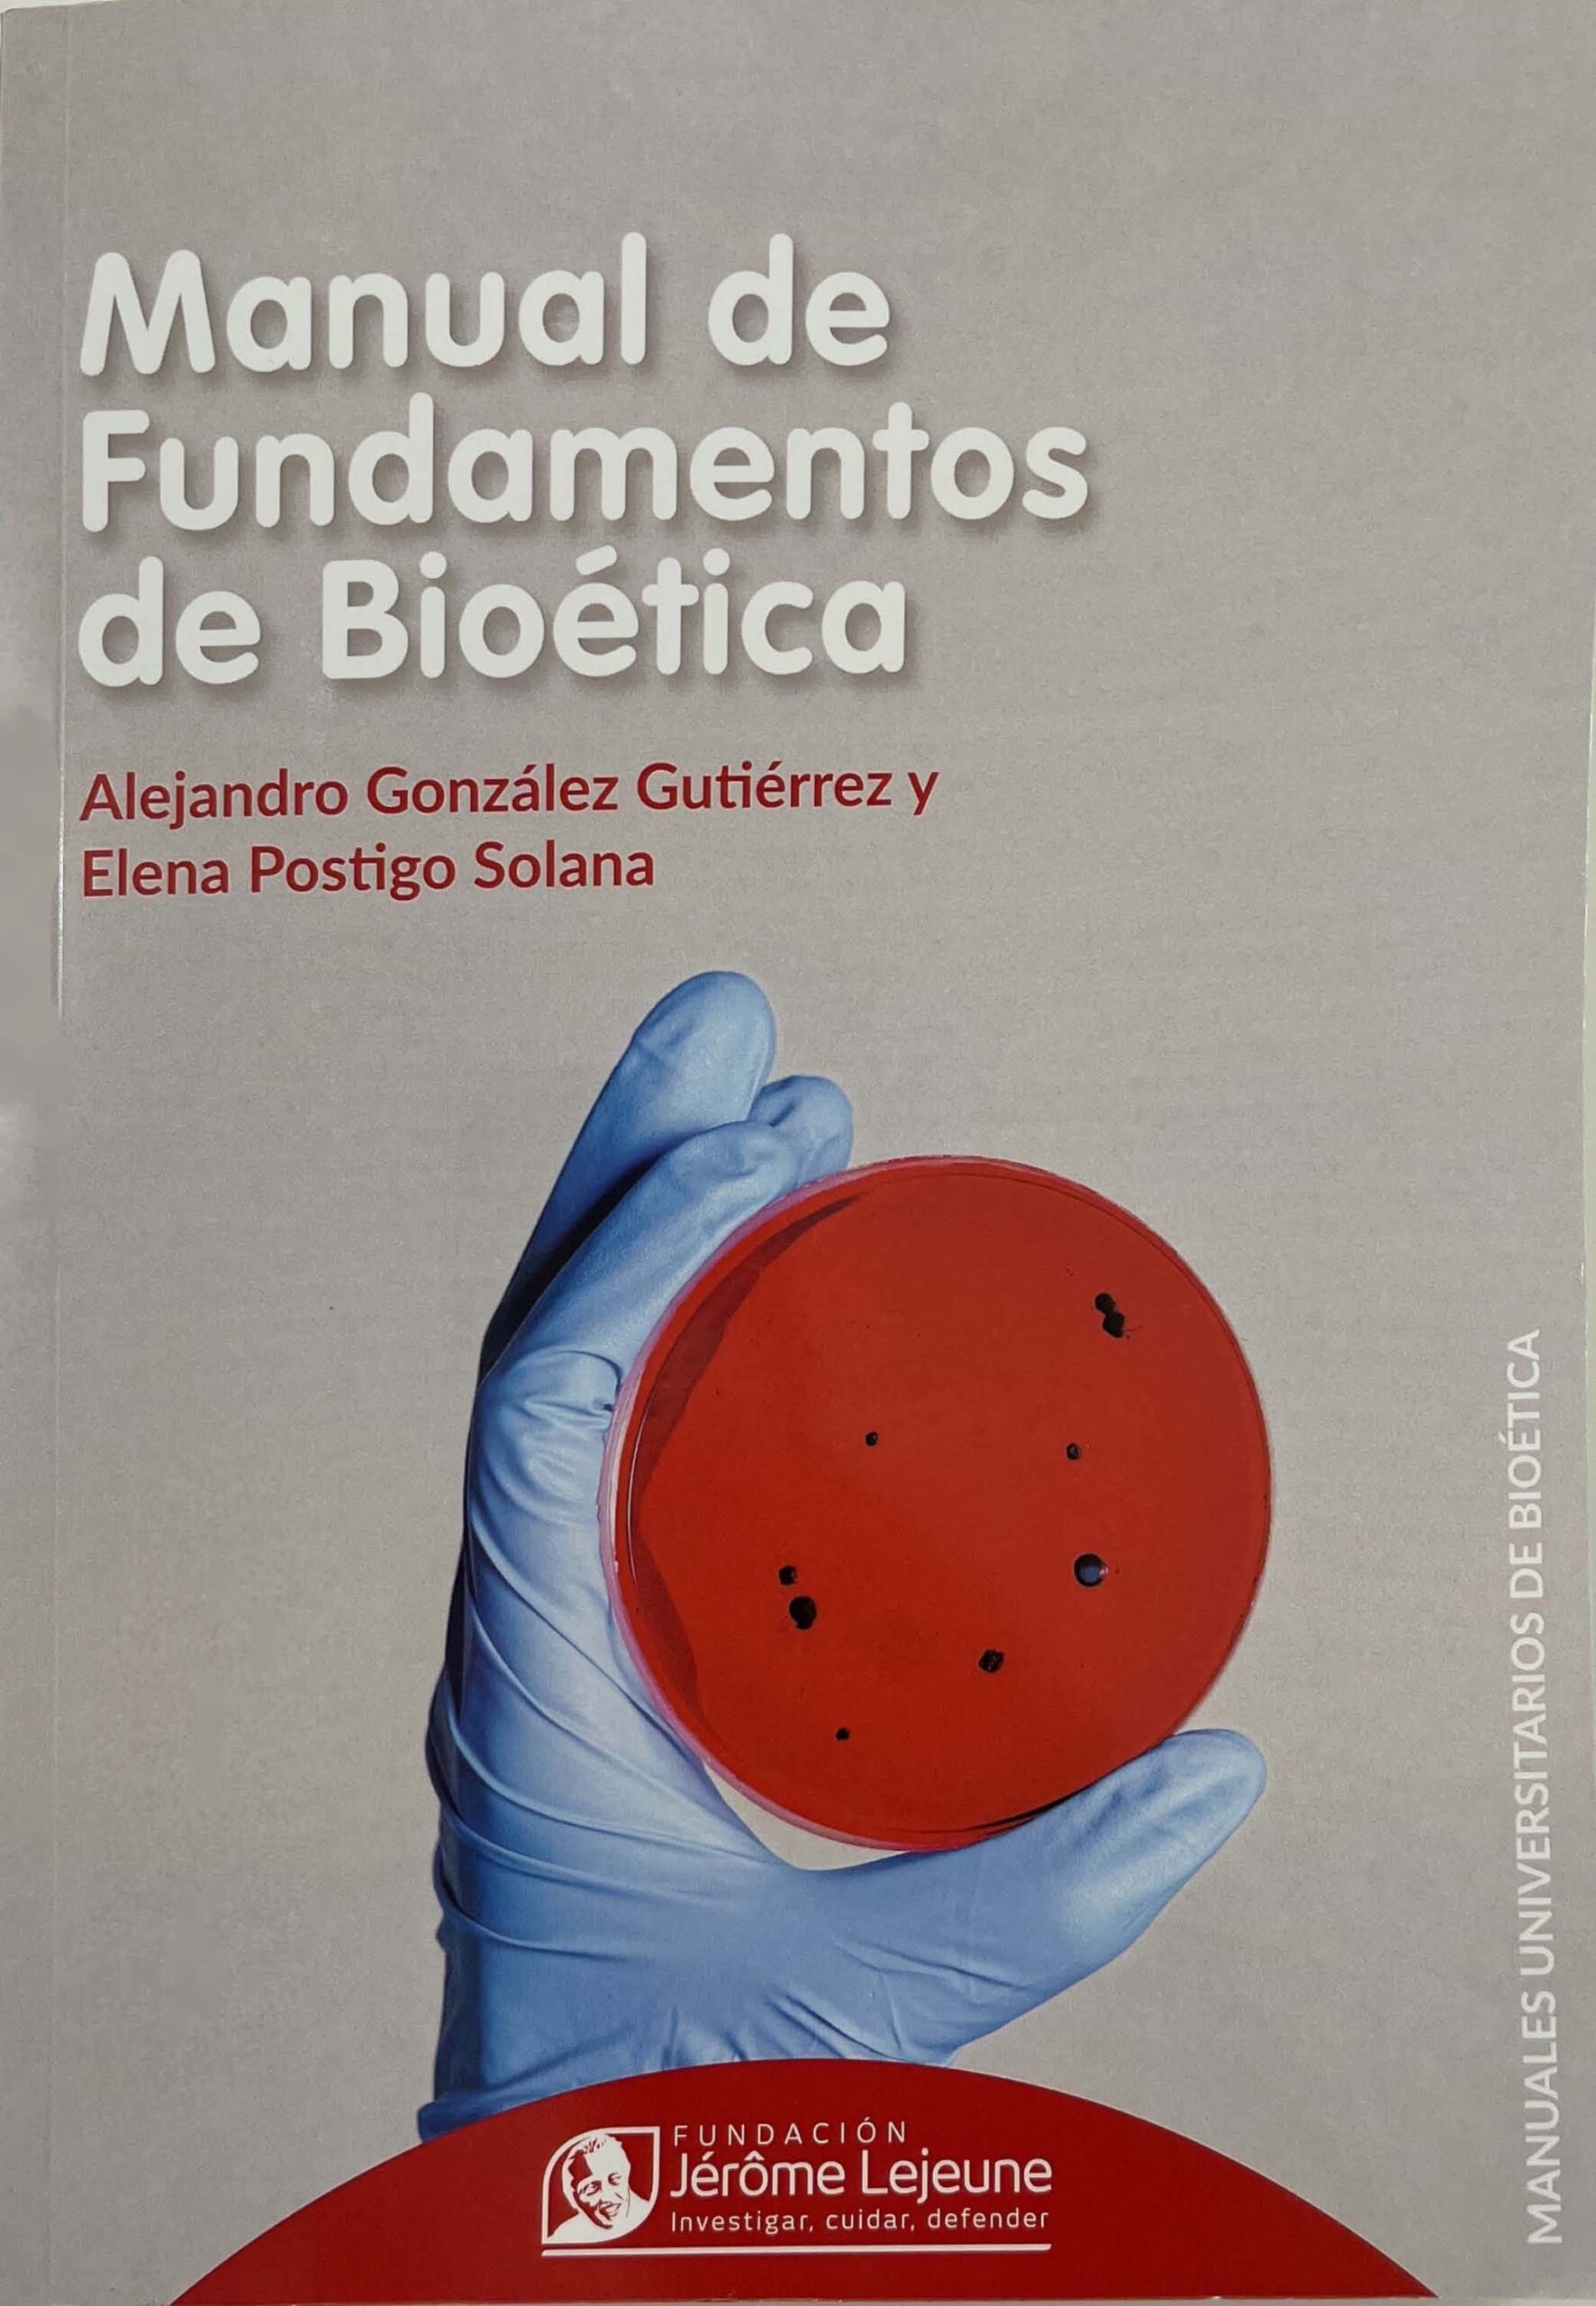

En este manual se recogen los fundamentos de la Bioética, sus orígenes históricos, su estatuto epistemológico, definición, metodología y corrientes en bioética, desde el principialismo hasta el personalismo ontológico y el transhumanismo. Una visión completa de los fundamentos filosóficos necesarios para adentrarse en la Bioética. Se detiene especialmente en el personalismo con fundamentación ontológica, la metodología triangular de Elio Sgreccia y los conceptos de persona, dignidad y naturaleza humana.